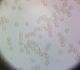

|
Last upload 2026-04-06 17:42:44
All photos copyrights reserved
Recent reports
Jackdaw
Corvus monedula - 2026-04-06 ligausis
Eurasian Sparrowhawk
Accipiter nisus - 2026-04-06 megemege
White Stork
Ciconia ciconia - 2026-04-06 ligausis
Tumšā eļļasvabole
Meloe proscarabaeus - 2026-04-06 Ziemelmeita
Three-toed Woodpecker
Picoides tridactylus - 2026-04-03 AtisL
Three-toed Woodpecker
Picoides tridactylus - 2026-04-03 AtisL
Great White Egret
Ardea alba - 2026-04-06 Osis
|
Recent comments on observations
Man šķiet, ka ir arī ciešākas grupiņas, 1. foto kreisajā malā. megere Zigurds Krievans Zivju gārnis 06.aprīlis, 12:18 Izskatījās pēc lietuvaiņiem, ierspējams kuitalas. megemege Paldies, Amanda! Es pārbaudīšu vai esmu pareizās bildes salikusi, tad arī jāizlabo! Kiwi Amanda a.b Ja, to jau biju ieziņojis atsevišķi. mufunja Paldies, Julita. Tev taisnība. Vienīgais, ka nav saaugušas grupās . megemege https://ebird.org/species/bahgoo megemege Labdien! Tā gaišā zoss ir Kalna zoss ( Anser indicus) . Gredzenots 27.06.2018 Kalnvēzes, Viesatu pagastā valters zaļš un zils augšā, uz kreisās kājas abiem baltajiem gredzeniem bij kaut kāda kaslīte. Amanda Kiwi Varētu būt lazda, sazāģēti sprunguļi zemē. zemesbite mufunja Derētu kāds biotopa foto, ja būtu, vai vismaz apraksts Tie laikam tie sēra izgulsnējumi, nezinu, kur tādus likt Paldies, tad jau viss sakrīt :) Ziemelmeita Satrūdējusi kritala mežā, nav dēļi. Iespējams, egle, jauktu koku mežs. Ziemelmeita Visdrīzāk Koksnesmušas Xylophagus sp. kūniņa Ziemelmeita Jā, zem mizas uz nokaltušas priedes. Lemmus Ja novērojums ielikts ne no aplikācijas, tad foto vajag pievienot pēc tam, t.i., tagad. gunitak gunitak spiigana Tev bija taisnība, nebija neievērotā, bet Smita vālenīte, kas reti tiek noteikta :) adata Julitai taisnība, sēne. Pieskaroties vālītes put, kātiņos nelūzt. Ļoti jauks paraugs. Nemikroskopēju (ceru kādreiz..), bet pēc ārējām pazīmēm izskatās pārliecinoši :) Physarum leucophaeum pēc kopskata ļoti ticama versija Labs. Nez vai ievākts?! Vēl Didymium serpula izskatīšanā Jā, varbūt zeltmatu Physarum flavicomum Man velk uz lākturītēm (Cribraria) Ja tā vieta bija ar ļoti mitru mikroklimatu, tad es teiktu, ka Diderma ochraceum Ļoti labi, paldies, interesanti. Tad jau tiksim skaidrībā! guta7 Julita, paldies par skaidrojumu un milzīgo ieguldījumu, palīdzot noteikt un izprast gļotsēnes! V.Grigorjevs 04.aprīlis, 01:06 Edgars Smislovs adata adata adata adata Mari Byssonectria sp. Pēc šādiem attēliem grūti precīzi pateikt B.terrestris vai B.fusispora spiigana Uz kā auga? Uz kritalas? Ja to, protams, var atcerēties :)) Ziemelmeita Paldies,Julita,par labojumiem un precizējumiem! mufunja Varbūt Ph.album, bet dikti skaists paraugs, pārbaudīšu Kiwi Paldies, Uģi, par sugas noteikšanu! Mari Mari Tās kārtīgās armijas rindās un blīvās čupiņas auga vienā vietā? Un, jā, visi varētu būt viena suga. Paldies, interesanti! Pats mežs - vecs? Jo līdz šim šī suga atrasta tikai izcilos, vecos mežos. finesse Mari Ja būs paraugs, tad pārbaudīšu, vai nav Ph.leucopus Par melno nav pārliecības, vai tā nav cieta sēne, bet tām rozā vajadzētu būt aveņgļotsēnēm Mežirbe777 Vienā bildē varbūt baltu dibenu redz... Tad mainām sugu uz S. difformis? zemesbite Protams, mikroskopiski derētu pārbaudīt Ņemot vērā, ka purvā, tai vajadzētu būt potenciāli aizsargājamajai sugai Tur varētu būt pat vairākas sugas vigulis Šai sugai prasās foto vai noteikšanas pazīmju aprakstu. Vai tomēr nebūs lielais ķīris? vigulis Šai sugai prasās foto vai noteikšanas pazīmju aprakstu. Vai tomēr nebūs lielais ķīris? zemesbite Siona a.b Varbūt arī tā. Ierakstīt nepaguvu.. forelljjanka Mazais dzenis.Agrākajam novērojumam Latvijā nepietiks.;) Mežirbe777 adata ekologs Manuprāt, koku kamene (Bombus hypnorum). adata Mežirbe777 Mežirbe777 adata Tik skaisti izkritusi no kausiņiem! megemege adata Pēc staipīgajiem kapilīcija pavedieniem un dzeltenās krāsas teiktu, ka režģa gļotsēne. Vai aplikācija ir atjaunināta? spiigana mufunja Mežirbe777 Mežirbe777 zane_ernstreite Varētu būt Reticularia lycoperdon zemesbite Vai dieniņ, kā tādu kunkulīti var ieraudzīt! Lieliski! :) zemesbite Pēdējā foto zobiņi labi redzami. ekologs Koksngrauzis (Obrium cantharinum). Lietuviete Liels paldies, Edgar, par sugas noteikšanu! guta7 Paldies par skaidrojumu. Ilgi cīnījos, lai tiktu skaidrībā. ekologs adata Ziemelmeita Paldies, kāpurs nokrita, vēl bildes dabūt nesanaca. Jā, grūti saprast, bet vismaz R.inqisitor tas nav. Ziemelmeita Vienīga bilde. Pietuvināju šo pašu, bet nekas īpaši labāks nav. Šis neizskatās pēc R.inqisitor kāpura. Varbūt kāda tuvāka bilde? Ziemelmeita adata Vai tik nebūs medainā bumbulīte? Augļķermeņi vertikāli izstiepti, sporu mākonis ciešā klājienā. Siona ekologs zemesbite pustumsa Iespējams peļu klijāna ligzda, kurš tur blakus cīnījās ar vārnām pustumsa Šķiet plucināja vistu no blakus esošās mājas pagalma Lielais meža raibenis sāk lidot ap jāņiem :) ekologs Gredzens HA39.922. Aizsūtīšu kolēģiem. adata ekologs Zeltmalu airvabole (Dytiscus marginalis). megemege Amanda S.gracilis/hyperopta, būtu skaidrāk jāredz sīkās sporas adata Piekrītu Julitai, gļotsēni neatgādina. Vairāk tā kā pēc sēnes - fleogenas izskatās.. Ziemelmeita Ivars Leimanis Ticamāk kalnu divzobe Orthodicranum montanum. Dubults Mani vienmēr samulsina šis tik pazīstamais saīsinājums - C. nigra - attiecībā uz gļotsēnēm :) Vīksna Vai tiešām pelēkais tāds koks un tik agri zied ? C.nigra tā izjukt kā alta nemaz nespēj. Kaut ko te jāizvēlas, izvēlos retāko. Amanda marsancija LMM 25.marts, 19:49 Macrogastra borealis (latesriata) LMM 25.marts, 19:47 Mežirbe777 Chaenotheca furfuracea (L.) Tibell Mežirbe777 |